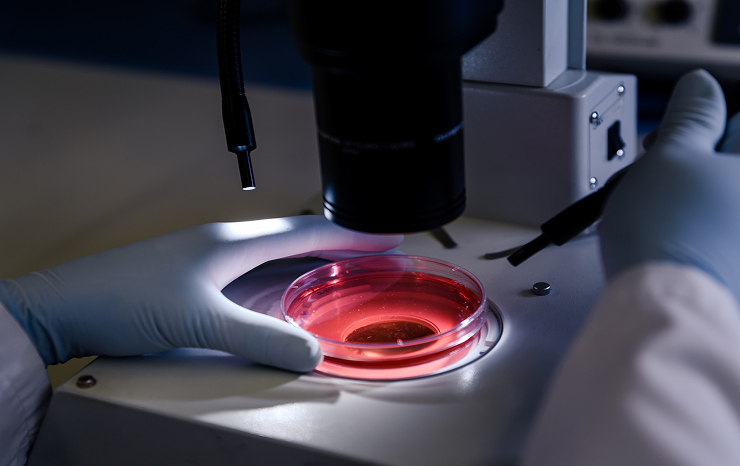

Ellie Kim
Jacob Harrison is the driving force behind EastNiuz, bringing over two decades of experience in the journalism and media. As the Publisher, Robert has dedicated himself to ensuring EastNiuz remains a trusted source of news that informs, engages.
Jacob’s vision for the EastNiuz is shaped by his belief in accessible and transparent news. He works closely with the editorial team to promote insightful, unbiased coverage across diverse topics, from global politics to local culture.